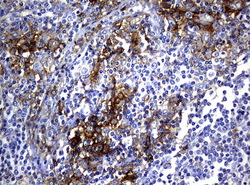

Antibody data
- Antibody Data
- Antigen structure
- References [0]
- Comments [0]
- Validations
- Western blot [1]
- Immunohistochemistry [12]
- Other assay [1]
Submit
Validation data
Reference
Comment
Report error
- Product number
- UM500051 - Provider product page

- Provider
- OriGene
- Proper citation
- OriGene Cat#UM500051, RRID:AB_2629065
- Product name
- FCGR2A mouse monoclonal antibody, clone UMAB60
- Antibody type
- Monoclonal
- Description
- FCGR2A mouse monoclonal antibody, clone UMAB60
- Host
- Mouse
- Conjugate
- Unconjugated
- Epitope
- FCGR2A
- Isotype
- IgG
- Antibody clone number
- UMAB60
- Vial size
- 100 µl
- Concentration
- 1.00mg/ml
No comments: Submit comment
Supportive validation
- Submitted by
- OriGene (provider)
- Main image

- Experimental details
- Western blot of human tissue lysates (15ug) from 10 different tissues (1: Testis, 2: Omentum, 3: Uterus, 4: Breast, 5: Brain, 6: Liver, 7: Ovary, 8: Thyroid 9: Colon, 10: Spleen). Diluation: 1:500.
- Validation comment
- WB
Supportive validation
- Submitted by
- OriGene (provider)
- Main image

- Experimental details
- Immunohistochemical staining of paraffin-embedded Human breast tissue using anti-FCGR2A mouse monoclonal antibody. (UM500051; heat-induced epitope retrieval by 10mM citric buffer, pH6.0, 120C for 3min)
- Submitted by
- OriGene (provider)
- Main image

- Experimental details
- Immunohistochemical staining of paraffin-embedded Adenocarcinoma of Human breast tissue using anti-FCGR2A mouse monoclonal antibody. (UM500051; heat-induced epitope retrieval by 10mM citric buffer, pH6.0, 120C for 3min)
- Validation comment
- IHC
- Submitted by
- OriGene (provider)
- Main image

- Experimental details
- Immunohistochemical staining of paraffin-embedded Adenocarcinoma of Human colon tissue using anti-FCGR2A mouse monoclonal antibody. (UM500051; heat-induced epitope retrieval by 10mM citric buffer, pH6.0, 120C for 3min)
- Validation comment
- IHC
- Submitted by
- OriGene (provider)
- Main image

- Experimental details
- Immunohistochemical staining of paraffin-embedded Human lung tissue using anti-FCGR2A mouse monoclonal antibody. (UM500051; heat-induced epitope retrieval by 10mM citric buffer, pH6.0, 120C for 3min)
- Validation comment
- IHC
- Submitted by
- OriGene (provider)
- Main image

- Experimental details
- Immunohistochemical staining of paraffin-embedded Carcinoma of Human lung tissue using anti-FCGR2Amouse monoclonal antibody. (UM500051; heat-induced epitope retrieval by 10mM citric buffer, pH6.0, 120C for 3min)
- Validation comment
- IHC
- Submitted by
- OriGene (provider)
- Main image

- Experimental details
- Immunohistochemical staining of paraffin-embedded Adenocarcinoma of Human ovary tissue using anti-FCGR2A mouse monoclonal antibody. (UM500051; heat-induced epitope retrieval by 10mM citric buffer, pH6.0, 120C for 3min)
- Validation comment
- IHC
- Submitted by
- OriGene (provider)
- Main image

- Experimental details
- Immunohistochemical staining of paraffin-embedded Human prostate tissue using anti-FCGR2A mouse monoclonal antibody. (UM500051; heat-induced epitope retrieval by 10mM citric buffer, pH6.0, 120C for 3min)
- Submitted by
- OriGene (provider)
- Main image

- Experimental details
- Immunohistochemical staining of paraffin-embedded Carcinoma of Human prostate tissue using anti-FCGR2A mouse monoclonal antibody. (UM500051; heat-induced epitope retrieval by 10mM citric buffer, pH6.0, 120C for 3min)
- Validation comment
- IHC
- Submitted by
- OriGene (provider)
- Main image

- Experimental details
- Immunohistochemical staining of paraffin-embedded Carcinoma of Human bladder tissue using anti-FCGR2A mouse monoclonal antibody. (UM500051; heat-induced epitope retrieval by 10mM citric buffer, pH6.0, 120C for 3min)
- Validation comment
- IHC
- Submitted by
- OriGene (provider)
- Main image

- Experimental details
- Immunohistochemical staining of paraffin-embedded Human lymph node tissue using anti-FCGR2A mouse monoclonal antibody. (UM500051; heat-induced epitope retrieval by 10mM citric buffer, pH6.0, 120C for 3min)
- Validation comment
- IHC
- Submitted by
- OriGene (provider)
- Main image
- Experimental details
- Immunohistochemical staining of paraffin-embedded Human lymphoma tissue using anti-FCGR2A mouse monoclonal antibody. (UM500051; heat-induced epitope retrieval by 10mM citric buffer, pH6.0, 120C for 3min)
- Submitted by
- OriGene (provider)
- Main image

- Experimental details
- Immunohistochemical staining of paraffin-embedded Human colon tissue using anti-FCGR2A mouse monoclonal antibody. (UM500051; heat-induced epitope retrieval by 10mM citric buffer, pH6.0, 120C for 3min)
- Validation comment
- IHC
Supportive validation
- Submitted by
- OriGene (provider)
- Main image

- Experimental details
- OriGene overexpression protein microarray chip was immunostained with UltraMAB anti-FCGR2A mouse monoclonal antibody (UM500051). The positive reactive proteins are highlighted with two red arrows in the enlarged subarray. All the positive controls spotted in this subarray are also labeled for clarification.
- Validation comment
- 10K-CHIP